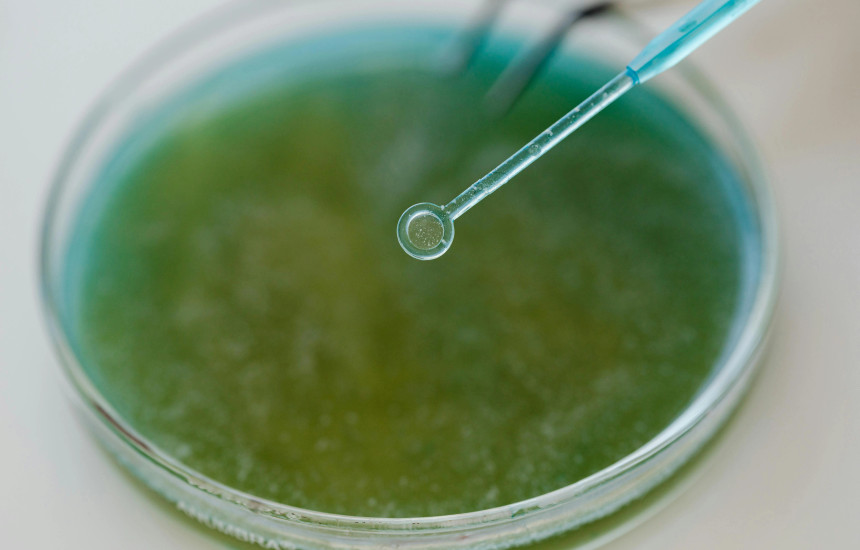
Bakteret

Përdorimi i antibiotikëve në fëmijëri mund të krijojë kushte për bakteret që prodhojnë një kimikat të rrezikshëm
Një toksinë në zorrë, që quhet kolibaktina, e lidhur prej më shumë se 20 vjetësh me kancerin e zorrës së trashë, mund të jetë një ndër shkaqet kryesore të rritjes shqetësuese të këtij kanceri te të rinjtë. Ky është përfundimi i një studimi të ri të publikuar në revistën shkencore Nature, ka raportuar NBC News.
Sipas studiuesve nga Universiteti i Kalifornisë në San Diego, disa baktere të dëmshme në zorrë, përfshirë lloje të caktuara si E. coli, Klebsiella pneumoniae dhe Citrobacter koseri, prodhojnë toksinën kolibaktinë (colibactin). Kjo toksinë, siç është treguar në studime që nga mesi i viteve '2000, shkakton dëme të veçanta në ADN-në e qelizave të zorrës, dëme që është vështirë të riparohen dhe që mund të çojnë në zhvillimin e kancerit.
Mbështete KOHËN. Ruaje të vërtetën.
Gazetaria profesionale është interes publik. Mbështetja juaj ndihmon që ajo të mbetet e pavarur dhe e besueshme. Kontribuoni edhe ju. 1 euro e bën dallimin.
Letër lexuesit — pse po kërkojmë mbështetjen tuaj KontribuoKy dëm në ADN është veçanërisht i dukshëm te njerëzit që zhvillojnë kancer të zorrës së tarshë në moshë të re. Në studimin e fundit, u analizuan tumoret e 981 pacientëve nga 11 vende të botës. U zbulua se mutacionet e lidhura me kolibaktinën ishin 3.3 herë më të shpeshta te pacientët nën 40 vjeç, krahasuar me ata mbi 70 vjeç.
“Rreth 50% e rasteve të kancerit të hershëm të zorrës së trashë tek individët nën 40 vjeç mbanin gjurmë të ekspozimit ndaj kolibaktinës”, ka thënë profesori Ludmil Alexandrov, autor kryesor i studimit dhe profesor i mjekësisë molekulare në UC San Diego.
Ky zbulim mund të jetë vendimtar për shëndetin publik, pasi rastet e kancerit të zorrës së trashë te të rinjtë po rriten me ritme të shpejta. Vetëm dy vjet më parë, Shoqata Amerikane e Kancerit ka raportuar se rastet e diagnostikimit te personat nën 55 vjeç janë dyfishuar mes viteve 1995 dhe 2019, me rritje të rasteve në fazë të avancuar me rreth 3% në vit te personat nën 50 vjeç.
“Kjo toksinë mund të jetë pjesa thelbësore e mozaikut”, ka thënë doktori Christopher Johnston, nga MD Anderson Cancer Center.
Sipas profesor Alexandrovit, dëmtimi nga kolibaktina mund të nisë që në fëmijëri, ndoshta që në dekadën e parë të jetës. Kjo nënkupton se ndryshimet në stilin e jetesës gjatë 40 vjetëve të fundit mund të kenë krijuar kushte që këto baktere të përhapen më lehtë te fëmijët.
“Ka disa hipoteza të mundshme, përfshirë përdorimin e hershëm të antibiotikëve, i cili mund të lejojë kolonizimin e këtyre baktereve, dieta moderne me më shumë ushqime të përpunuara dhe më pak fibra; rritja e lindjeve me operacion (C-seksion), ulja e gjidhënies dhe rritja e kujdesit në grupe (çerdhe) në moshë të hershme, që lehtëson përhapjen e mikrobeve gjatë një faze të ndjeshme të zhvillimit”, ka thënë Alexandrov.
Megjithatë, shumë pyetje mbeten pa përgjigje.
Doktori, Shuji Ogino, profesor në Universitetin e Harvardit, ka thënë se ende nuk dihet nëse disa njerëz janë më të ndjeshëm ndaj efektit të kolibaktinës, apo nëse kjo lidhet drejtpërdrejt me stilin e jetesës.
Përveç baktereve që prodhojnë kolibaktinë, edhe mikrobe të tjera si Fusobacterium nucleatum janë lidhur me zhvillimin e kancerit të zorrës së tarshë. Alexandrov ka sugjeruar se ndoshta kolibaktina shkakton mutacionet fillestare, ndërsa mikrobe si F. nucleatum ndihmojnë tumoret të përhapen dhe t’i shpëtojnë sistemit imunitar.
“Ndërveprimi mes mikrobeve mund t'i shumëfishojë këto efekte. Për shembull, te pacientët me sindromën trashëguese familial adenomatous polyposis, është parë se kur bashkekzistojnë Bacteroides fragilis dhe E.coli që prodhon kolibaktinë, dëmtimi i ADN-së është shumë më i madh”, ka thënë Johnson.
Në dy deri në tre vjetët e ardhshme, studiuesit synojnë të krijojnë një test jo-invaziv që përdor mostra të jashtëqitjes për të identifikuar gjurmët e kolibaktinës, dhe kështu të përcaktojnë rrezikun për zhvillim të hershëm të kancerit.
“Qëllimi është të identifikojmë njerëzit që janë në rrezik të lartë para se sëmundja të shfaqet. Këta individë duhet të kontrollohen rregullisht”, ka thënë Alexandrov.
Duke pasur parasysh provat gjithnjë e më të shumta për rolin e kolibaktinës, studiuesit tani po shqyrtojnë edhe masa parandaluese, si probiotikë të synuar apo vaksina specifike.
“Ndërhyrjet e synuara për të eliminuar këto baktere janë të justifikuara. Një vaksinë për fëmijë që krijon kujtesë imunitare kundër E. coli që prodhon kolibaktinë mund të jetë hapi tjetër”, ka thënë Johnson.
Megjithatë, ai ka shtuar se një vaksinë e tillë do të kërkojë shumë kohë për të dhënë rezultate.
“Është një projekt afatgjatë që kërkon vite, ndoshta dekada, për të parë nëse ndikon vërtet në uljen e rasteve të kancerit te të rinjtë”, ka thënë Johnson.